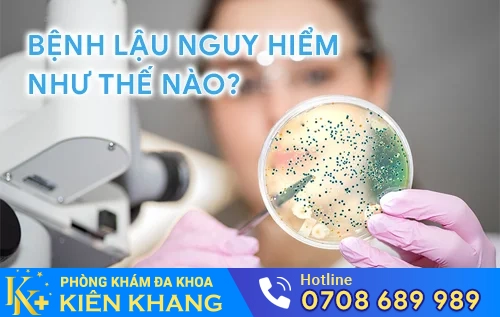
hieu biet benh lau cung bac si chuyen khoa

Chi Phí Chữa Bệnh Lậu Năm 2026 Là Bao Nhiêu?
Để được tư vấn cụ thể hơn hãy BẤM VÀO KHUNG CHAT bên dưới hoặc...
Hình Ảnh Chi Tiết Bệnh Lậu Tại Các Vùng Khác Nhau Trên Cơ Thể
Để được tư vấn cụ thể hơn hãy BẤM VÀO KHUNG CHAT bên dưới hoặc...
Bệnh Lậu Và Những Dấu Hiệu Bệnh Khó Phát Hiện
Hãy gọi ngay đến 0708 689 989 hoặc bấm vào khung chat dưới đây để được tư...
Bệnh Nổ Bô Có Nguy Hiểm Không? Phương Pháp Chữa Bệnh Nổ Bô Hiệu Quả
Để được tư vấn cụ thể hơn hãy BẤM VÀO KHUNG CHAT bên dưới hoặc...
Bệnh Lây Qua Đường Tình Dục Và Những Điều Có Thể Bạn Chưa Biết
Để được tư vấn cụ thể hơn hãy BẤM VÀO KHUNG CHAT bên dưới hoặc...
Nguy Cơ Ung Thư Vòm Họng Từ Bệnh Lậu Đường Miệng
Để được tư vấn cụ thể hơn hãy BẤM VÀO KHUNG CHAT bên dưới hoặc...
Những Nguy Hiểm Từ Bệnh Lậu Ở Nữ Giới Mà Bạn Cần Nắm Rõ
Để được tư vấn cụ thể hơn hãy BẤM VÀO KHUNG CHAT bên dưới hoặc...
Vô Sinh và Nguy Cơ Tử Vong Cao Với Nam Giới Mắc Bệnh Lậu
Để được tư vấn cụ thể hơn hãy BẤM VÀO KHUNG CHAT bên dưới hoặc...
Hiểu Biết Về Bệnh Lậu Cùng Bác Sĩ Chuyên Khoa
Để được tư vấn cụ thể hơn hãy BẤM VÀO KHUNG CHAT bên dưới hoặc...
Dấu Hiệu Của Bệnh Lậu Là Gì? Cách Điều Trị Hiệu Quả Nhất?
Để được tư vấn cụ thể hơn hãy BẤM VÀO KHUNG CHAT bên dưới hoặc...
- 1
- 2